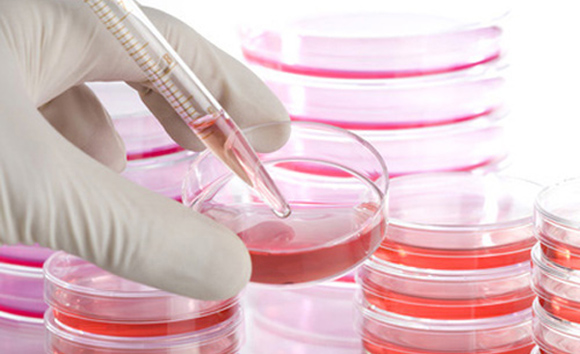
细胞培养服务

万千商家帮你免费找货
0 人在求购买到急需产品
- 详细信息
- 询价记录
- 技术资料
- 提供商:
澳音生物
- 服务名称:
细胞培养服务
- 规格:
--
上海澳音生物科技有限公司,于2020年在上海市嘉定区登记注册,注册资金100万,主要从事生物技术领域内的技术开发、技术咨询、技术转让和技术服务,实验室设备及耗材、化工原料及产品、塑料制品的销售。目前公司处于初创高速发展阶段,公司成员均为本科及以上学历。公司有着相当规模的细胞库,专业提供细胞及细胞相关产品,与上海及周边部分科研院校,医院及医药高新企业有着密切合作;另有代理进口实验室设备,为客户整套服务。秉承客户第一的理念,以最合理的价格,最贴心的服务,为广大客户提供最全面的生物产品;我们坚信,为客户提供真实、高品质的服务是公司⻓期生存发展的源泉!期待您的咨询和⻅证
风险提示:丁香通仅作为第三方平台,为商家信息发布提供平台空间。用户咨询产品时请注意保护个人信息及财产安全,合理判断,谨慎选购商品,商家和用户对交易行为负责。对于医疗器械类产品,请先查证核实企业经营资质和医疗器械产品注册证情况。
- 作者
- 内容
- 询问日期
技术资料暂无技术资料 索取技术资料
细胞培养服务
询价

![萤火虫荧光素酶-稳转株构建[LUC]](https://img1.dxycdn.com/2023/0727/998/2530814543982044861-14.jpg!wh200)




